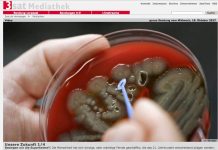
„Besiegen wir die Superkeime?“

Kfz-Versicherungen richtig vergleichen
"Pressemitteilung"
Stichtag 30. November: Worauf Kunden achten sollten
Jetzt flattern wieder die Beitragsrechnungen der Kfz-Versicherungen ins Haus. Kunden sollten Preise und Konditionen genau prüfen: Bis zum 30. November können sie Policen kündigen und so mitunter mehrere hundert Euro sparen. Doch welche Kriterien sind beim Vergleich wichtig? Die Verbraucherzentrale Niedersachsen gibt Tipps zu möglichen Einsparungen und unverzichtbaren Leistungen.
Das Einsparpotenzial hängt vom Einzelfall ab. „Fahranfänger können durch einen Wechsel der Kfz-Versicherung im Extremfall bis zu 1.500 Euro sparen, ein langjährig unfallfrei gefahrene Senior hingegen ‚nur‘ knapp 600 Euro“, erklärt Maximilian Gehr, Versicherungsexperte der Verbraucherzentrale in Braunschweig. Jedoch sei nicht nur der Preis entscheidend. Folgende Tipps sollten Kunden beachten:
1. Nicht übereilt kündigen: Schon die Umstellung auf einen aktuellen Tarif beim bisherigen Versicherer kann sich lohnen. Kunden sollten aktiv nachfragen.
2. Leistungen prüfen: Empfehlenswert bei Kfz-Haftpflichtversicherungen sind erhöhte Deckungssummen für Personen-, Sach- und Vermögensschäden (100 Millionen sowie mindestens 12 Millionen als Maximaldeckung je geschädigter Person) sowie die sogenannte Mallorca-Police. Wichtig in der Teil- und Vollkaskoversicherung sind zudem der Verzicht auf die Einrede der groben Fahrlässigkeit und der erweiterte Schutz bei Tierschäden und Marderbissen.
Ringvorlesung Digitalisierung und Mobilität
RECHT erfolgreich – Ausbildung in der Rechtsanwalts- oder Steuerkanzlei
Die verborgene Sprache der Blumen
Dirigent der Lüfte – Fluglotse werden
„Wir formen Mobilität“ im BiZ Braunschweig
Gelenkmittel: Von wirkungslos bis riskant
"Pressemitteilung"
Nahrungsergänzungsmittel im Test der Verbraucherzentralen
25 Nahrungsergänzungsmittel im Marktcheck der Verbraucherzentralen
Nutzen der Produkte bei Gelenkerkrankungen fraglich, Zulässigkeit der Werbeversprechen zweifelhaft
Verbraucherzentralen fordern strengere Regelungen und Kontrollen
Gelenkmittel sollen gegen Arthrose helfen oder die Knorpelmasse schützen – so verspricht es die Werbung der Hersteller. Die Verbraucherzentralen haben 25 Nahrungsergänzungsmittel auf ihre Dosierung, Zusammensetzung und Werbeversprechen geprüft. Das Ergebnis: Der Nutzen der Produkte bei Gelenkerkrankungen oder -beschwerden ist fraglich, die Zulässigkeit der Werbeaussagen zweifelhaft. Häufig sind die Mittel zu hoch dosiert und können zum Teil sogar gesundheitliche Risiken mit sich bringen. Die Verbraucherzentralen setzen sich für mehr Transparenz ein und fordern strengere gesetzliche Regelungen und Kontrollen für Nahrungsergänzungsmittel.
„Besiegen wir die Superkeime?“
"Diese Frage steht im Zentrum der ersten Folge von "Unsere Zukunft". Weltweit wird der Einsatz von Antibiotika in der Massentierhaltung immer noch gesteigert. Die Folge: resistente Keime werden von Tieren auf Menschen übertragen und gelangen in die Nahrungskette. Die Weltgesundheitsorganisation WHO spricht von der vielleicht größten, globalen Gefahr dieses Jahrhunderts." Quelle 3sat
Multiresistente Keime, Antibiotika, Krankenhausinfektionen, Ursachen, Folgen, Zusammenhänge, Ausblick .... dazu ein aktueller Beitrag auf 3Sat, der in der Mediathek verfügbar ist
Mit Licht in die dunkle Jahreszeit
"Pressemitteilung"
Reparaturaktion der Fahrradinitiative
Wie schon in den letzten Jahren so heißt es auch am Samstag, dem 28. Oktober 2017, zwischen 14 und 18 Uhr wieder "Sei helle!“ Auf dem Platz der Deutschen Einheit reparieren Mitglieder der Fahrradinitiative in einer Lichtaktion kostenlos Lichtanlagen von 100 Fahrrädern. Beteiligt sind der ADFC-Braunschweig sowie Fahrradhändler wie Steinkamp, Velocity, Radspezial bzw. Hahne, die an den Reparaturstationen ehrenamtlich und unentgeltlich arbeiten. Die Lichtanlagen werden nach Bedarf mit neuen Komponenten ergänzt. Ziel der Lichtaktion ist, auf die Gefahren bei Radfahren ohne Licht aufmerksam zu machen. "Wir setzen uns dafür ein, dass die Radfahrer sicher unterwegs sind. Deswegen wollen wir dazu animieren, mit Licht Rad zu fahren, und machen Lichtanlagen an 100 Fahrrädern wieder funktionsfähig", bringt Sven Schröder vom ADFC das Engagement auf den Punkt. Die Verkehrswacht und die Polizei unterstützen die Aktion ebenfalls.